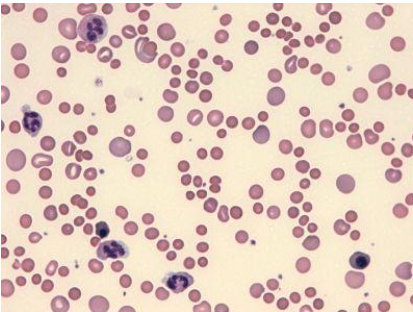

Anemia Hemolítica Autoimune
A anemia hemolítica autoimune é uma condição na qual autoanticorpos passam a reconhecer antígenos da membrana eritrocitária, o que desencadeia ativação do sistema complemento e aumento da fagocitose, reduzindo a sobrevida das hemácias e comprometendo a capacidade de transporte de oxigênio. Como esse processo decorre da quebra dos mecanismos de autotolerância, ele pode se manifestar de formas distintas conforme a temperatura de reatividade dos anticorpos, já que anticorpos quentes atuam em torno de 37°C e favorecem a hemólise extravascular, enquanto anticorpos frios se ligam aos eritrócitos em baixas temperaturas e intensificam a hemólise intravascular.
Embora seja relativamente rara, a doença pode surgir de modo primário ou ocorrer secundariamente a infecções, doenças autoimunes, neoplasias hematológicas ou uso de determinados medicamentos, e essa diversidade etiológica exige uma abordagem diagnóstica integrada. Assim, a análise combinada de hemograma, reticulócitos, bilirrubinas, LDH, haptoglobina e teste de antiglobulina direta torna-se indispensável, pois direciona a confirmação diagnóstica e esclarece os mecanismos predominantes de hemólise, além de reforçar a importância do profissional biomédico na interpretação precisa desses achados laboratoriais.
Mecanismos Imunológicos Envolvidos na Anemia Hemolítica
A anemia hemolítica autoimune ocorre quando o sistema imune perde a capacidade de reconhecer os eritrócitos como próprios e passa a produzir autoanticorpos contra glicoproteínas de superfície. Esses autoanticorpos, que podem ser IgG ou IgM dependendo da temperatura de reatividade, ligam-se às hemácias e desencadeiam hemólise extravascular ou intravascular. Essa interação não depende apenas da classe do anticorpo, mas também da eficiência de ativação do sistema complemento, já que a deposição de fragmentos como C3c e C3d intensifica a remoção das células pelo sistema reticuloendotelial.
A participação do complemento é central na fisiopatologia, pois sua ativação pode se limitar aos primeiros componentes, resultando apenas em opsonização e fagocitose, ou avançar até a formação do complexo de ataque à membrana, produzindo lise intravascular. Além disso, infecções virais, reações cruzadas com antígenos microbianos, uso de determinados medicamentos e falhas regulatórias de linfócitos T podem modificar antígenos eritrocitários ou desequilibrar a tolerância imunológica, favorecendo a produção de autoanticorpos patogênicos. Esses mecanismos explicam tanto a diversidade clínica quanto a variação da gravidade entre os diferentes tipos de AHAI.
Hemograma e Lâmina Periférica na Anemia Hemolítica
O hemograma e a avaliação da lâmina periférica são fundamentais na investigação da anemia hemolítica autoimune, pois demonstram alterações típicas da destruição acelerada das hemácias e da resposta medular. O hemograma geralmente revela anemia associada a reticulocitose, já que a medula óssea aumenta a produção de eritrócitos para compensar a perda periférica. Esse incremento eritropoético leva ao predomínio de macrócitos policromáticos, ao aumento do VCM e ao RDW elevado. Em alguns casos, pode haver leucocitose como resposta sistêmica ao processo hemolítico.
Na lâmina periférica, observam-se anisocitose, poiquilocitose, policromasia e esferócitos, que refletem perda de membrana eritrocitária induzida pela ação imunológica. Em quadros associados a anticorpos frios, a autoaglutinação pode estar presente. A identificação de esferócitos e, ocasionalmente, de esquizócitos auxilia no diagnóstico diferencial e reforça a presença de hemólise. A revisão da lâmina é indispensável, pois permite avaliar características específicas dos glóbulos vermelhos e verificar outras séries celulares, contribuindo para a exclusão de doenças hematológicas concomitantes.
Lâmina de paciente com AHAI.
Marcadores Bioquímicos da Hemólise na Anemia Hemolítica
Os marcadores bioquímicos permitem identificar e confirmar a hemólise, refletindo a destruição aumentada das hemácias e suas repercussões metabólicas. A análise integrada desses exames auxilia no diagnóstico, no monitoramento da gravidade e na diferenciação entre hemólise intra e extravascular.
Principais exames alterados:
- Bilirrubina indireta elevada: resultado do aumento na degradação da hemoglobina.
- LDH elevada: indica lise celular intensa e é frequentemente muito aumentada.
- Haptoglobina diminuída: reduzida pelo consumo após ligação à hemoglobina livre.
- Hemoglobinúria e hemossiderinúria: mais comuns na hemólise intravascular.
- Reticulocitose: representa a resposta medular à destruição eritrocitária.
Interferências e Cuidados Pré-Analíticos Importantes na Anemia Hemolítica
As etapas pré-analíticas influenciam diretamente a confiabilidade dos resultados, pois hemólise in vitro, escolha inadequada de anticoagulante, tempo prolongado entre coleta e processamento e condições inadequadas de transporte podem alterar valores hematológicos, bioquímicos e imunológicos; portanto, controlar variáveis como jejum, hidratação e uso de medicamentos, além de seguir rigorosamente os protocolos de coleta e conservação da amostra, é essencial para garantir resultados consistentes.
Conclusão
A compreensão integrada dos mecanismos imunológicos, das alterações hematológicas e dos marcadores bioquímicos envolvidos na anemia hemolítica autoimune permite esclarecer o quadro clínico e orientar decisões diagnósticas de forma precisa, enquanto o controle rigoroso das etapas pré-analíticas assegura a confiabilidade dos resultados. Dessa forma, unir conhecimento técnico e boas práticas laboratoriais é fundamental para interpretações seguras e para o manejo adequado do paciente.
O próximo passo de todo analista que deseja ter mais segurança na bancada
Todo analista que busca se destacar e se tornar um profissional mais atualizado, capacitado e qualificado para o mercado de trabalho precisa considerar uma pós-graduação.
Um profissional com especialização é valorizado na área laboratorial; esse é um fato inegável.
Unimos o útil ao agradável ao desenvolver uma pós-graduação em Hematologia Laboratorial e Clínica.
Para aqueles que procuram a comodidade de uma pós-graduação 100% online e ao vivo, sem abrir mão da excelência no ensino, temos a solução ideal.
Nossa metodologia combina teoria e prática da rotina laboratorial, garantindo um aprendizado efetivo.
Contamos com um corpo docente altamente qualificado, com os melhores professores do Brasil, referências em suas áreas de atuação.
No Instituto Nacional de Medicina Laboratorial, temos apenas um objetivo: mais do que ensinar, vamos tornar VOCÊ uma referência.
Toque no botão abaixo e conheça a pós-graduação em Hematologia Laboratorial e Clínica.
QUERO CONHECER TODOS OS DETALHES DA PÓS-GRADUAÇÃO
Referências:
MENDES, Rafaela da Silva; DIAS, João Leonardo Rodrigues Mendonça; MENDONÇA, Sérgio de; FREITAS, Lucas Alves de; SILVA, Luana Guimarães da; PARDI, Paulo Celso. Anemia hemolítica autoimune: introdução às formas de apresentação da síndrome e diagnóstico imuno-hematológico. Capítulo 6, 2020. Aceito em: 01 set. 2020. Submetido em: 12 ago. 2020.
SILVA, Thiago Gonzales Samaritano Villalpando. Anemia hemolítica autoimune: uma análise literária das alterações laboratoriais e morfológicas como ferramentas diagnósticas. 2024. Trabalho de Conclusão de Curso (Bacharelado em Biomedicina) – Universidade Federal do Rio Grande do Norte, Centro de Biociências, Natal, 2024.
RAMOS, Ana Beatriz Amorim; RIBEIRO, Anna Julia; DELFINO, Ketelyn Karolynne Santos; ALMEIDA, Luanna Silva; SILVA, Adriano Lopes da. Anemia hemolítica autoimune: uma revisão integrativa. e-Acadêmica, v. 3, n. 2, e8932258, 2022.
RANGEL, Renata Lígia Galvão; SOUZA, Yanik Loquet Peres de; SANTOS, André Mendonça dos. Diagnóstico laboratorial da anemia hemolítica autoimune. Revista de Empreendedorismo e Gestão de Micro e Pequenas Empresas, v. 6, n. 1, p. 180-201, jan./abr. 2021



